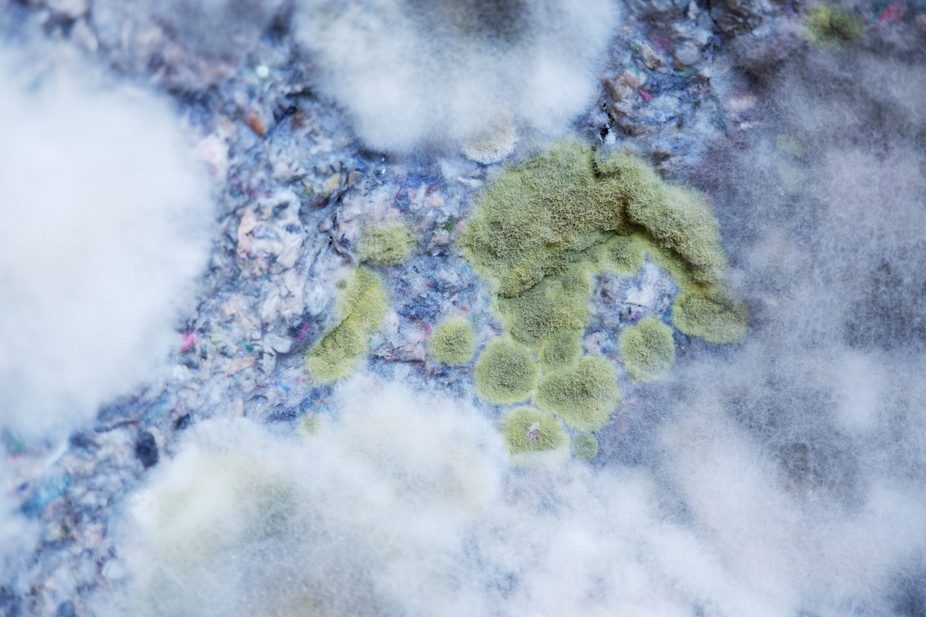
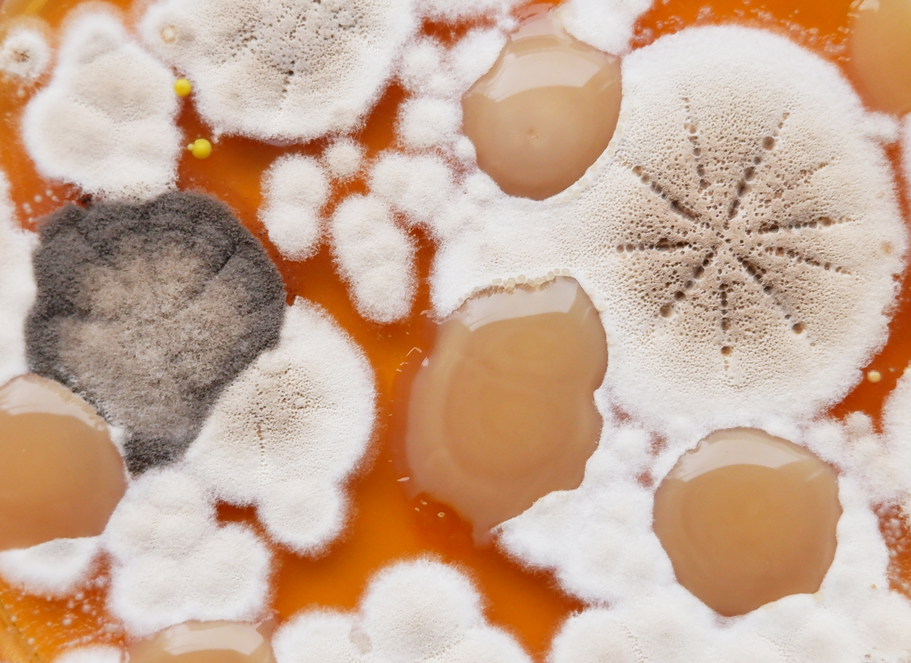
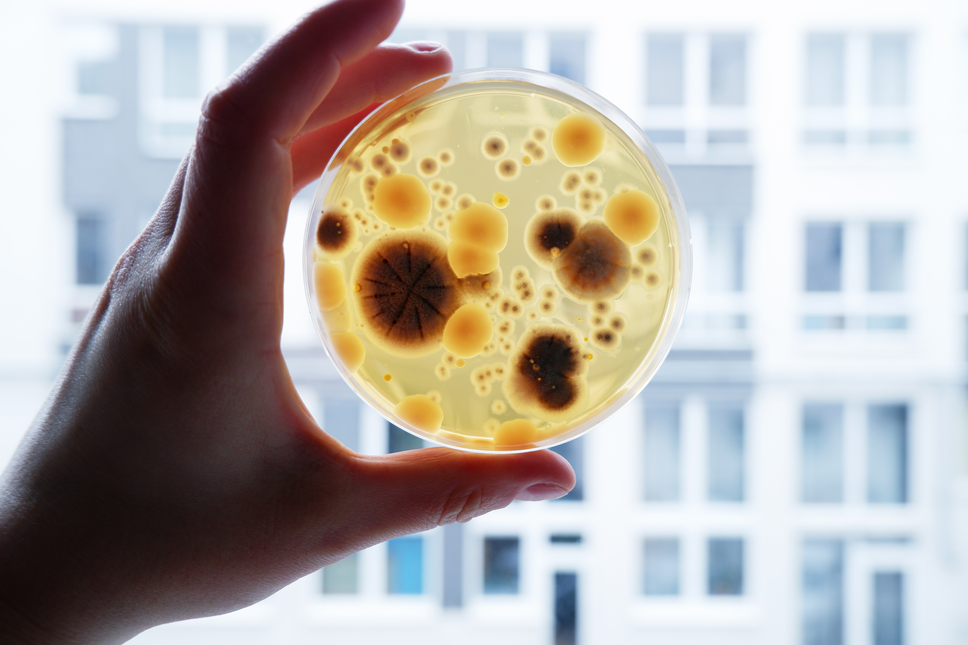

In today’s civilization of scientific technology and innovation, the main guarantee of future progress or even the survival of humanity is measured by materiality: it is a culture of materials that starts with the world’s largest mines, such as the Bingham Canyon mine in Utah, USA, which is about 4 kilometers wide and more than 1.4 km deep and is visible even from space[1], to millimeter copper cables that supply electricity to the farthest corners of the world to meet our daily needs[2].
Rapid technological progress and material culture are driving even greater demand for materials: new industrial plants are being created, centuries-old forests are cut down and replaced by new plantations, agricultural, livestock areas and existing mines are being expanded not only displacing wildlife and indigenous people from their long-term settlements but also transforming the planet’s natural surface. The rapid pace of life leaves practically no time to reflect on the impact it has on our lives and gradually transforms a human into a resident of synthetic civilization.
[1] NASA, NASA Photo ID ISS015-E-29867, Date taken 2007.09.20, Time taken 14.46.43 GMT, Spacecraft Altitude: 181 nautical miles (335km), 2007 [interactive], [accessed: 31 03 2021]: https://eol.jsc.nasa.gov/SearchPhotos/photo.pl?mission=ISS015&roll=E&frame=29867
[2] ENTSO-E, Transmission System Map, 2019 [interactive], [accessed: 31 03 2021]: https://www.entsoe.eu/data/map/
Eventually, plastic became synonymous with materiality, both metaphorically and literally, and a symbol of our synthetic civilization. Today, synthetic materials are used not only in the production of plastics but also in the construction of cities, cars, furniture, household products, clothing, and disposable packaging; they are even used as an ingredient in cosmetics and beauty products in the form of microplastics. Studies show that microplastic particles are frozen in Antarctic glaciers, fall from the sky or fly in the air, and are found in the oceans at depths of thousands of meters. From here, the microplastics enters the digestive tract of seafood and fish, travels to our food plates, and eventually ends up to the human body as well. According to the data of recent studies, microplastic particles are found even in the placenta of unborn babies. Scientists are not yet sure how microplastics have reached the bloodstream or what effect this has on pregnancy and fetal development. According to dr. Antonio Ragusa, director of the UOC midwifery and gynecology hospital in Rome, where the study was conducted, this is alarming: “if we find something in the placenta, it means we will find it in the baby as well... It is like a baby cyborg that is no longer made up of human cells alone, it is a mixture of biological and inorganic substances[3].”
[3] Global NEWS, 'Matter of great concern': Scientists find microplastics in human placenta for 1st time, 2020 [interactive], [accessed: 31 03 2021]: https://globalnews.ca/news/7537031/microplastics-human-placenta-fetus-study/
Rapidly evolving regenerative medicine and 3D printing technologies are driving the trend of analyzing living materials: synthetic meat is grown from animal cells, which could potentially replace today’s cattle meat and reduce the need for livestock farming and the environmental pollution it creates; simple human organs are grown, such as ears or skin, which soon could be used for the treatment of injuries or even for the reconstruction of functioning human organs. Internationally, living materials design is increasingly improving and gaining popularity as a new field of alternative art and design. However, in my current practice, I do not seek to examine the field of living materials design as a separate topic, because it is a kind of new and very broad topic covering issues of human biological conception and design ethics. I invite wild nature and microorganisms to join as creative assistants and co-authors who would accelerate the biodegradation of hybrid materials objects and represent the natural processes of material transformation.
How do different shapes of objects affect thechoreography of living materials and wild nature and how do they adapt or do not adapt to the new structural reality? What new properties of materials are created, and which ones are lost and how the material specification boundaries are pushed? And how can we free ourselves from the anthropocentric perception of the relationship between humans and nature by “looking” from a material perspective?
It is assumed that raising these issues and incorporating wild nature and microorganisms into creative processes provide an opportunity to find a new knowledge.
Even though the human body is gradually becoming a hybrid of living and synthetic materials, there are many natural polymers, bacteria, and microorganisms in our body and on the entire planet, and perhaps even in space, with which we can collaborate and explore opportunities and conditions for new material futures to become more flexible and aware of the unexpected changes that may await us.
This collaboration with nature is a research created during my stay at the Montemero art residency in Spain, during which I explored the possibilities of natural materials and primitive technology while using only site-specific materials. The ingredients were sourced from less than 100 meters radius around the residency, to reflect the sustainability and show the natural beauty of unique local materials.
I accidentally found a lot of sand-clay material mixture in a garden which led me to explore the technology of the mud-brick processing.
The bricks were used to create a land art installation
in our lifetime we eat 20kg of plastic!
that’s more plastic than the two mobile recycling bins which only weigh 10kg each
During the Montemero art residency, I encountered wild rabbits in the area, which led me to research their digestive system and their feces. Rabbits are the animals which reingest their own droppings in order to use nutrients. these types of feces are commonly known as ‘night droppings’ and are eaten immediately after defecation.
For me, this was a remarkable example of the circular economy in nature and a great chance to experiment with an alternative and naturally “recycled” cellulose-based material.
After weeks of collecting and processing the materials, I created a hay-like biocomposite material made of crushed rabbit feces and bind together using a starch-based bioplastic.
During my collaboration with nature in TUO TUO art residency this august, I found that our neighbour is keeping a horse. my material research is mainly based on cellulosic materials, so I was super happy when I had a chance to try a horse manure material which is a naturally recycled cellulose.
I shaped few abstract objects by hand while trying out the different material combinations: it contains fallen tree branches, pine sap and jute fiber, horse manure, local rowanberries and bird seeds.
The project was created in collaboration with nature and for nature - especially for wild birds. I install those objects in a natural environment and continue on my research while exploring how different shapes of objects affect the local bird’s eating habits.
These biodegradable objects could be consid- ered as independent things, changing with time, and creating their own story while trans- forming into new hybrid materials and coming back into different layers of the Earth.
This project was a result of an experimental practice that was aimed at finding a substance for synthetic plastic using only natural resources which would later on form a new cycle of nature.
After a lot of experiments of mixing natural ingredi- ents, I created a new biodegradable material based on a seaweed. This new material perfectly holds its shape, is waterproof, and protects the product against possible damage. made of only two natural ingredients, this material is wholly organic and compostable.
After the product is consumed, its packaging can simply be composted or used as a fertiliser. Even if this packaging has been discarded as waste, due to natural processes and microorganisms it will again become a part of nature, forming new layers of chalk, and will cause no harm to the environment or other forms of life.
During a TUO TUO art residency I tried a birch tar making process, because my current material research is about making things in a primitive way with as fewer resources and energy as possible. The TUO TUO residency was a perfect place for my technological material experiments because, the dominant tree species in Finnish forests are downy birch (Betula pubescens), and silver birch (Betula pendula) together with spruce and pine.
In this research, I upgraded my black matter material which I created a few years ago during a "SoftLab" Residency and Scholarship Program at Sliperiet Umeå University, Sweden. At this time I tried to change the cellulose-based bioplastic with a more organic material extracted straight from nature and processed in a more primitive and more environmentally friendly way than industrial bioplastic.
The birch tar was made from the dry distillation of the bark of birch trees. This process is really old. There is evidence that people were dry distilling birch tar in what is now Germany 40,000 years ago to make the glue necessary to create weapons for hunting. The material has very similar properties to bioplastic and could be used as a binder for composite materials or as a waterproof agent that is organic and biodegradable.
The complexity of the processes around us is constantly changing - adapting to different environmental conditions or disappearing as a result of humanity. However, perhaps the human influence on the processes of a big natural change which bringing the sixth extinction it's only the natural consequence of this civilization and the process of shaping the future world that we can observe and experience today. at this time in the anthropocene period, the biggest challenge we face is philosophical: to realize that this civilization is already dead. The sooner we face our situation and realize that there is nothing we can do to save ourselves, the sooner we will be able to solve the difficult task of adapting to our new reality. In the short term, we should inevitably rethink our relationship with the environment and answer the question: if art is now doomed to a world that "breaks down" as a direct part of the sediment of human activity, how can creative practices be addressed to social, cultural and political spheres that will survive only in the thin geological layer of the earth?
This is an ongoing project of natural materials research and investigation of landscape assimilation while speculating on possible future scenarios on a macro and micro scale. The vision of the future is presented through bioplastic artefacts - a series of material assimilation experiments and documentation of the relationship with the natural surface of the biosphere.
living material experiments with creative co-authors - bacteria
growing various random bactria on agar plates
living material experiments with creative co-authors - fungi
growing blue mold (Penicillium italicum) on sticky rice and recycled paper mass